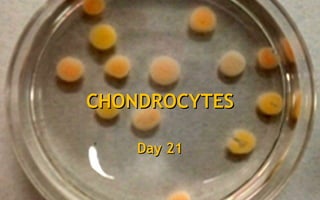
Day 3Day 3Day 5Day 5Day 7Day 7Day 21Day 21
CHONDROCYTESCHONDROCYTES

This document describes cellular and proteomic products from LIFEbankTM, an ISO9001 registered global supplier of human biological tools. It provides information on their disease-specific products including cellular products like neurospheres, adipose stromal cells, skin fibroblasts, and bone marrow mononuclear cells. It also lists various crude protein lysates and over 20 disease areas they provide associated cellular and proteomic products for, ranging from amyotrophic lateral sclerosis to idiopathic thrombocytopenia.